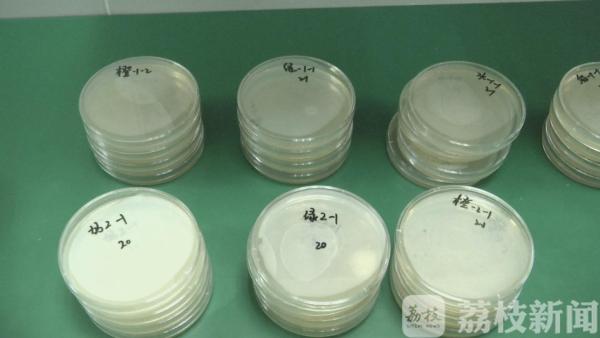

秋季干燥,大家应该多喝水,喝水看似普通,其实也有讲究。最近,网上流传着“隔夜水有毒、千万不能喝”的说法,让不少人感到担忧。这些说法有依据吗?怎样喝水更加安全、健康?
有网帖宣称,隔夜水最好不要饮用,因为放了一夜的水,会被细菌污染,继而产生亚硝酸盐。由于亚硝酸盐是致癌物,因此就有了隔夜水有毒的说法。记者在街头随机采访了50位市民,80%的人表示,曾经喝过隔夜水。

采访中记者发现,不少人在饮料开瓶之后,一时没法喝完,又不想浪费,就将饮料放进了冰箱,有时甚至一放就是两三天。而针对奶制品,绝大多数市民表示,隔夜的肯定不能喝。
记者在超市分别购买了矿泉水、绿茶、果汁和牛奶。
根据实验要求,每种饮料各买两瓶。志愿者将这四种饮料各开启一瓶,现场喝上一口,再重新盖上盖子。之后,喝过的饮料和没有开封的饮料一起存放在专业实验室里,等待第二天进行检验。经过24小时后,检测员分别对喝过之后隔夜存放的饮料和没有喝过的饮料取样,进行大肠杆菌以及菌落总数的检测。
两天后,实验有了结果,没有喝过的饮料细菌检测均达标。而喝过的饮料中,牛奶里的某菌种菌落总数已经超标,绿茶、果汁则未检测出超量细菌,矿泉水24小时样和48小时样均有较多细菌,并呈爆发式增长。检测员表示,已经喝过的绿茶、果汁饮料未检出细菌,是由于里面添加了抑制细菌的添加剂。

检测员介绍,饮料中富含糖分,尤其是牛奶、咖啡还含有部分蛋白质,这些恰恰是细菌繁殖所需要的营养物质。在本次实验中,四件样品未检测出大肠杆菌,饮料检测出的细菌量都在可允许的范围内。不过专家说了,在实验中志愿者只是喝了一口,相对来说污染的概率会小很多。在实际生活中,污染的几率会高很多。
另外专家表示,细菌的生长条件是根据温度变化来决定的,如果温度相对较高,它的生长繁殖会快很多。

实验结果说明,隔夜饮料细菌的繁殖速度从快到慢,依次为:牛奶>矿泉水>果汁>茶类,尽管细菌达到一定的量才可能致病,但专家建议,开封后的饮料,尤其是牛奶和矿泉水,如果动嘴喝过,隔夜之后最好不要饮用。
专家建议,无论什么饮料,尽量都在当天饮用完,或者不接触嘴巴,另倒在杯子里喝,避免病从口入。
(来源:《零距离》记者/胡艳 扬州台 编辑/赵梦琰)








 公安备案号:32010202010067
公安备案号:32010202010067
我要说两句